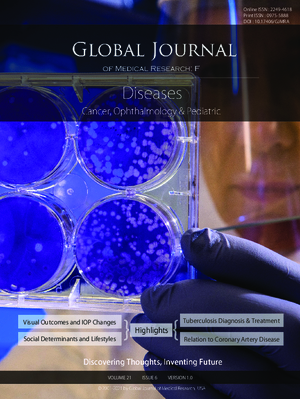
GJMR-F Diseases: Volume 21 Issue F6

-

GJMR-F Diseases: Volume 22 Issue F6
Vol. 22 No. F6 (2022) -

GJMR-G Veterinary Science and Veterinary Medicine: Volume 22 Issue G1
Vol. 22 No. G1 (2022) -

GJMR-J Dentistry and Otolaryngology: Volume 21 Issue J3
Vol. 21 No. J3 (2021) -

GJMR-E Gynecology and Obstetrics: Volume 21 Issue E4
Vol. 21 No. E4 (2021) -

GJMR-C Microbiology and Pathology: Volume 21 Issue C3
Vol. 21 No. C3 (2021) -

GJMR-I Surgeries and Cardiovascular System: Volume 21 Issue I3
Vol. 21 No. I3 (2021) -

GJMR-B Pharma, Drug Discovery, Toxicology and Medicine: Volume 21 Issue B3
Vol. 21 No. B3 (2021) -

GJMR-E Gynecology and Obstetrics: Volume 21 Issue E3
Vol. 21 No. E3 (2021) -

GJMR-C Microbiology and Pathology: Volume 21 Issue C2
Vol. 21 No. C2 (2021) -

GJMR-A Interdisciplinary: Volume 21 Issue A3
Vol. 21 No. A3 (2021) -

GJMR-K Interdisciplinary: Volume 21 Issue K7
Vol. 21 No. K7 (2021) -

GJMR-H Orthopedic and Musculoskeletal System: Volume 21 Issue H2
Vol. 21 No. H2 (2021) -

GJMR-K Interdisciplinary: Volume 21 Issue K8
Vol. 21 No. K8 (2021) -

GJMR-J Dentistry and Otolaryngology: Volume 21 Issue J2
Vol. 21 No. J2 (2021) -

GJMR-B Pharma, Drug Discovery, Toxicology and Medicine: Volume 21 Issue B2
Vol. 21 No. B2 (2021) -

GJMR-E Gynecology and Obstetrics: Volume 21 Issue E2
Vol. 21 No. E2 (2021) -

GJMR-F Diseases: Volume 21 Issue F7
Vol. 21 No. F7 (2021) -

GJMR-G Veterinary Science and Veterinary Medicine: Volume 21 Issue G2
Vol. 21 No. G2 (2021) -

GJMR-F Diseases: Volume 21 Issue F8
Vol. 21 No. F8 (2021) -

GJMR-I Surgeries and Cardiovascular System: Volume 21 Issue I2
Vol. 21 No. I2 (2021) -

GJMR-K Interdisciplinary: Volume 21 Issue K6
Vol. 21 No. K6 (2021) -

GJMR-F Diseases: Volume 21 Issue F4
Vol. 21 No. F4 (2021) -

GJMR-F Diseases: Volume 21 Issue F3
Vol. 21 No. F3 (2021) -

GJMR-F Diseases: Volume 21 Issue F5
Vol. 21 No. F5 (2021) -
GJMR-F Diseases: Volume 21 Issue F6
Vol. 21 No. F6 (2021)